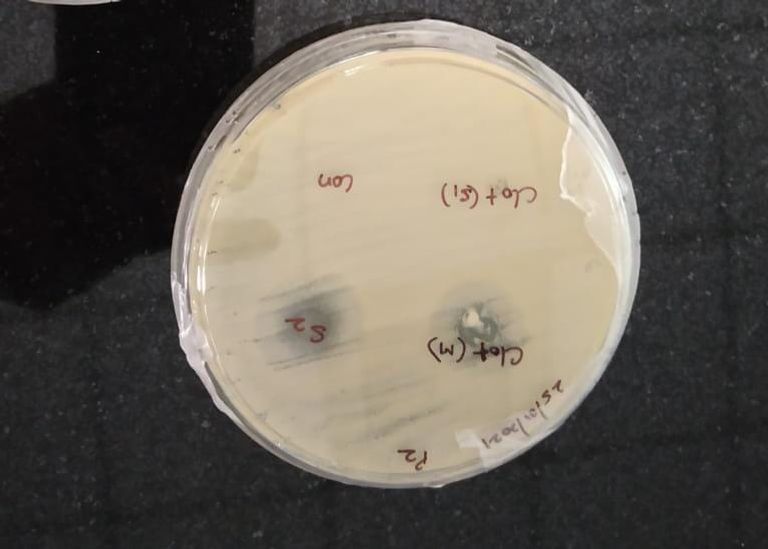
الباحث اليمني الدكتور نبيل عبدالله الباهلي

"العين الإخبارية" تحاور باحثا يمنيا طوّر تقنية طبية فريدة

لاقى حصول باحث يمني على براءة اختراع من الهند، بعد ابتكاره تقنية طبية فريدة من نوعها، اهتماما واسعا.
الباحث الدكتور نبيل عبدالله الباهلي قادته تجاربه العلمية إلى اختراع طريقة جديدة بتقنية مبتكرة تساعد على وصول الدواء إلى الجسم بشكل فعال متغلباً على نظام توصيل الأدوية التقليدية.
هذا الإنجاز الطبي الذي يحسب لشباب اليمن وعقولها المهاجرة، دفع "العين الإخبارية" للتواصل مع الباحث اليمني، وإجراء حوار خاص معه، لمعرفة تفاصيل ابتكاره العلمي الذي مثّل إشراقة أمل لبلد تطحنه الحرب بلا هوادة.

الطريق نحو الابتكار
يحكي الدكتور الباهلي لـ"العين الإخبارية" بداياته العلمية، منذ التحاقه بأكاديمية "جي إس إس" للتعليم والبحث العالي، في أبريل/نيسان 2018، تحت إشراف الدكتور "أميت بي باتل" في كلية الصيدلة، قسم الصيدليات.
وهناك في الأكاديمية الهندية "جي إس إس" قام الدكتور الباهلي ببلورة فكرة المشروع وعمل عليه لفترة طويلة من حيث التجارب الأساسية في المختبر.
يضيف الباحث اليمني: "بفضل الله حصلت على نتائج مرجوة قادتني إلى براءة الاختراع التي حصلت عليها من مكتب براءة الاختراع الهندي بتاريخ 30 يناير/كانون الثاني 2022".
ويؤكد الباهلي أن الأدوية التي تم تسجيل براءة الاختراع عليها هي من مشتقات الـ"إيميدازول"، وهي الـ"كلوتريمازول وكيتوكونازول وفوريكوناز"، وهذه الأدوية تعمل كمضادات للفطريات.
كيفية عمل العقار
ويشرح الباحث اليمني تفاصيل عمل التقنية الذي نال بموجبها براءة الاختراع من الأكاديمية الهندية، مشيرًا إلى أن العقار لديه الكثير من المميزات.
ويقول: "تتمثل مميزات التقنية في أنها عبارة عن غشاء رقيق شفاف غير لاصق يمكن أن يزيد من وقت التلامس ووصول الدواء إلى جسم المريض".
ويساهم الابتكار في إطلاق الجرعات الفاعلة باستمرار بما يضمن تأثيرات علاجية أقوى مقارنة بالأدوية الأخرى كالمستحضرات الموضعية أو المراهم.

حوافز الاختراع
براءة الاختراع شكلت حافزًا مهمًا بالنسبة للدكتور نبيل الباهلي، سواءً على المستوى العلمي أو المهني، حيث يؤكد أنها "تفتح لي آفاقًا كثيرة في رصيدي العلمي والوسط الأكاديمي، سواءً في بلدي الحبيب أو في بلد آخر"، وفق قوله.
ويواصل: "وكذلك في الجانب المهني، أكسبني هذا الابتكار مهارات عديدة من حيث بلورة الأفكار الصيدلانية، وآلية العمل الأساسي والحديث في المختبر، والتعامل مع مراحل تطوير الدواء وآلية عمله".
ولم ينسَ الباهلي تقديم شكره وامتنانه لما وصفها بـ"بلده الثاني الهند" التي كان لها رحابة الصدر مع الطلاب والباحثين اليمنيين بشكل عام، وجامعته التي هيأت له كل معاملها وأدواتها وموادها.
كما لم يغفل بلاده الأم اليمن، وقال: "بلدي الحبيب أدعو الله صباحًا ومساءً أن يرفع عنه هذا البلاء، ولقد أخذنا على عاتقنا حين نعود إلى أرض الوطن بناء ورفعة بلدنا، ولن نستريح أو يهدأ لنا بال، حتى نرى بلدي الحبيب يصنع مليون دواء".

شركات أدوية تغازل الباهلي
وتعتزم الجريدة الرسمية في مكتب براءات الاختراع الهندي نشر المزيد من التفاصيل عن تقنية الدواء الجديد في الأيام المقبلة.
ولفت هذا الاختراع المميز الذي ابتكره الباحث اليمني، أنظار شركات الأدوية، التي سعت إلى استثمار العقار، وتطويره ونشره بهدف إيصاله إلى المرضى، وتحقيق مردود صحي ومالي أيضا.
وبالفعل، طلبت إحدى شركات الأدوية من الدكتور الباهلي العينات التي تم تطويرها.
ووفق مصادر، فإن شركة منتجة بدأت بالتواصل لطلب عينات من الصيغ التي تم تطويرها ونشرها في مكتب براءات الاختراع الهندي، بهدف إنتاج كميات تجارية من العقار.






